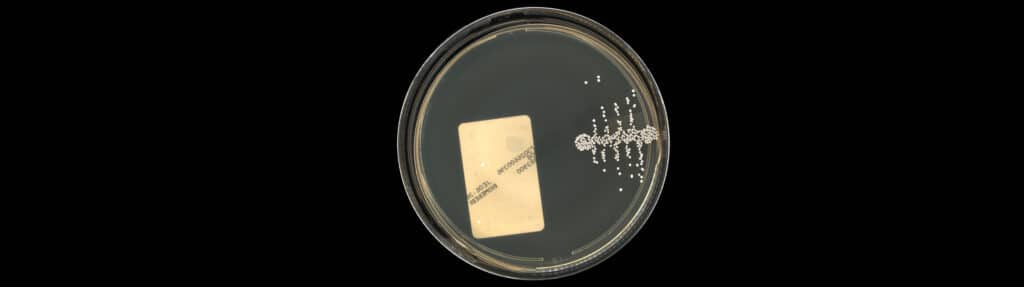
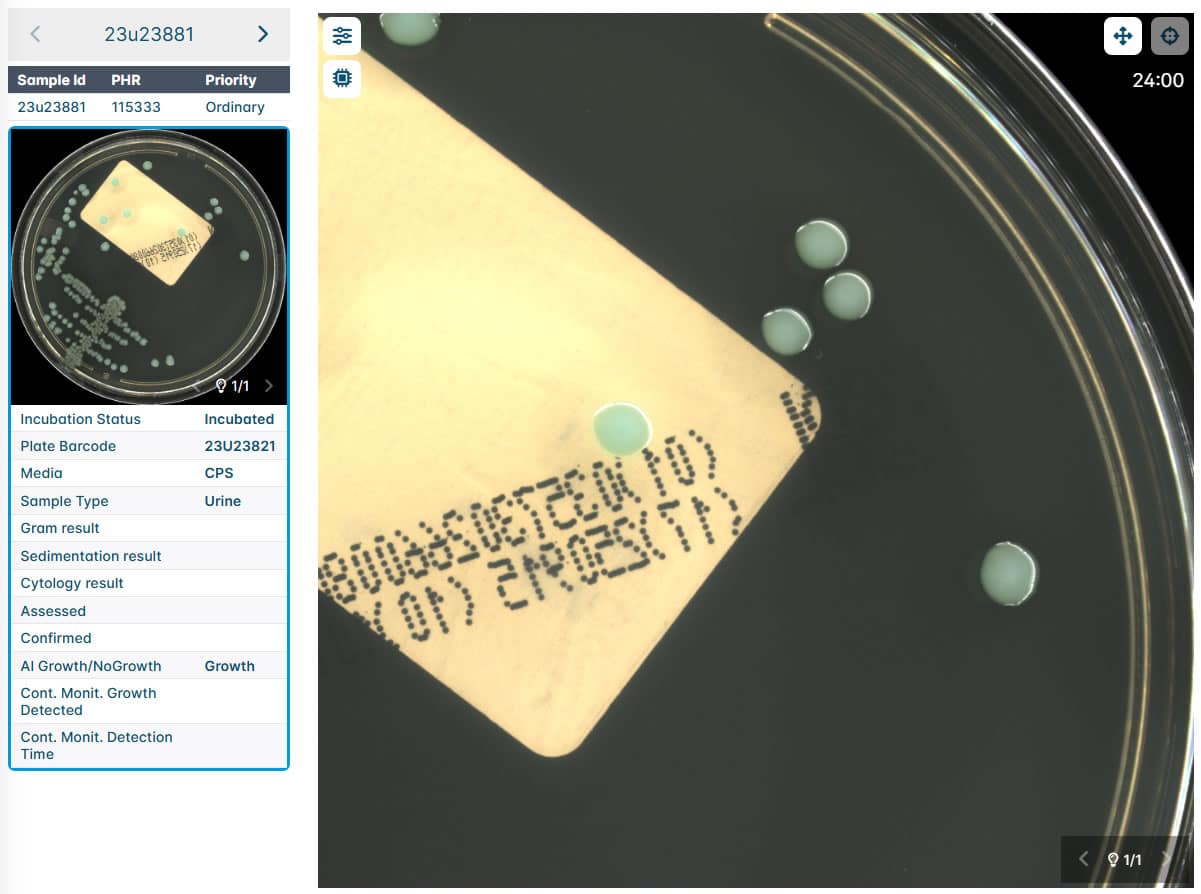

The AIPLAK incubates and digitalises samples, streamlining interpretation for technicians. Its compact, modular design with independent cameras and dual image capture introduces efficient tools for workflow management based on sample criticality.

Automated Incubator & Plate Assessment Track
The AIPLAK first incubates biological samples under controlled conditions to ensure optimal growth. Then, it digitalises the samples with high precision, streamlining interpretation and accelerating workflows for laboratory technicians.
Additionally, it can be complemented with unique AI modules capable of providing continuous monitoring of critical samples.

AIPLAK offers modular, efficient, and accurate incubation through a dual 2-chambers incubation system. These chambers are fully customizable to align with laboratory protocols, enhancing flexibility and precision in the incubation process while ensuring optimal performance across various applications.

A specialized desktop application that ensures efficient data management, error reduction, and full workflow digitization. Designed to meet various laboratory needs, it digitally manages and identifies samples, enhancing
efficiency by eliminating physical contact and optimizing processes for greater precision and productivity.

The device sorts output samples into different carriers according to their subsequent destination and/or sends them to trash when that is the technician’s decision during routine operation following established laboratory procedures guidelines.
High-quality and customizable incubation
Best footprint in the market with only frontal clearance required
Digitalisation of incubation, reading, and interpretation of samples
Connected or as standalone system, 2-independent incubation chambers
Dual imaging system
Minimal impact on daily operations

The graphical interface is designed to allow users to navigate easily and intuitively through all available features. It supports multiple users and profiles, providing personalized access and functionality according to each role. Its layout and structure offer a clear, user-friendly experience that simplifies daily operations and enhances workflow efficiency.
The system allows users to zoom in and out effortlessly while observing samples under different lighting conditions. This functionality provides enhanced visualization and flexibility, enabling detailed inspection of samples from multiple perspectives. By adjusting magnification and lighting, users can obtain a clearer and more comprehensive view, improving analysis accuracy and workflow efficiency.

Users can easily tag and define work-up processes, enabling clear identification and organization of each step. They can assign labels, categorize procedures, and configure parameters according to specific protocols. This functionality ensures accurate tracking, simplifies workflow management, and enhances overall efficiency in sample processing.

The intelligent incubation system is the only system on the market equipped with 2 complementary imaging systems. A first continuous monitoring system that allows uninterrupted monitoring of sample growth, being capable of generating alarms as soon as growth is detected in the sample. The second system captures the overhead image, digitising the sample and executing artificial intelligence algorithms to determine the characteristics of that growth. This advanced platform that combines time-based and growth-based management protocols, provides the laboratory with a unique tool to address emergency situations, to efficiently optimise workflow processes thus contributing to a more effective operation and accelerated results in the laboratory.
Accelerate detection with a
continuous monitoring system

It’s not about automation,
it is about adding value through automation
Contact us
Experience the future of Clinical Microbiology with AIPLAK. Accelerate detection with continuous reading excellence!